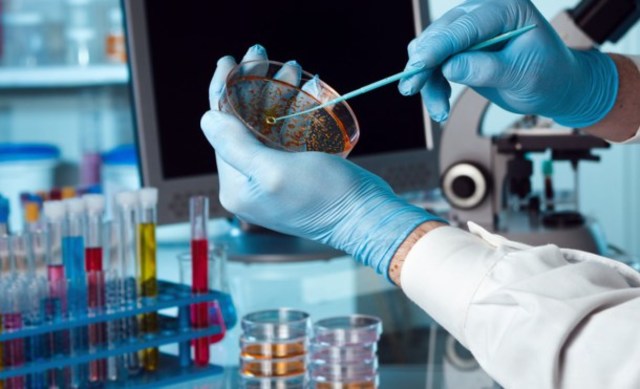
La biotecnología puede estar a punto de encontrar una cura contra el cáncer.

tecnologías emergentes a través de la historia y su contribucion en nuestro país durante los últimos 20 años en la sociedad cambiante
By Faraon13
-
La Fabricación Aditiva consiste en la superposición de capas micrométricas de material, normalmente en forma de polvo hasta conseguir el objeto deseado. La modalidad de fabricación trae una nueva revolución industrial, vinculada con el desarrollo de las TIC, y será pieza clave de la era digital y futuro industrial de los países desarrollados al permitir prescindir de herramientas de fabricación.Los sectores donde la Fabricación Aditiva ya se emplea son la automoción, la aeronáutica, la joyería.
-
Se crea el primer smartphone. fue un gran cambio para la comunicación tradicional que permitía no solo comunicarse sino guardar una mayor cantidad de información. prototipo apareció en 1992 y cuya venta comenzó en 1994.
-
Se lanza al mercado windows 95, una nueva versión en la cual se introdujeron mejoras significativas, tanto para mejorar el programa como para hacer mas fácil su utilización.siendo completamente distinta a las de versiones anteriores, y el pasar de usar una arquitectura multitarea cooperativa de 16 bits a usar una arquitectura multitarea apropiativa de 32 bits.
-
Fue en 1996 cuando HoTMaiL (con mayúsculas homenajeando HTML) se convirtió en el primer servicio de email on-line.
-
Google fue fundado en septiembre de 1998 por Larry Page y Sergey Brin, dos estudiantes de doctorado de Stanford.
-
La nueva generación de dispositivos portátiles se diseña para adaptarse a la forma del cuerpo humano. Estos dispositivos portátiles son olímpicamente pequeños, con una amplia gama de sensores y sistema de retroalimentación, y aspecto camuflado para que su uso sea menos intrusivo y socialmente más aceptable. entre ellos están las Google Glass, PS4, las prendas de vestir inteligentes, donde se puede incorporar sensores y electrónica miniatura para que cambien de color según lo desee el usuario.
-
Wikipedia fue lanzada en 2001 y se convirtió en la primera enciclopedia hecha por y para internautas de manera colaborativa. A día de hoy sigue entre nosotros y aumenta el número de artículos y de aportaciones de los internautas.
-
Xbox fue la primera videoconsola de sobremesa producida por Microsoft, en colaboración con Intel. Su principal característica es su procesador central basado en el procesador Intel Pentium III. El sistema también incorpora un lector de DVD, un disco duro interno, puerto ethernet y por último el sistema dispone de cuatro conectores para los mandos. Las unidades vendidas de este equipo fueron 24 millones de consolas, según las cifras oficiales.
-
es un sitio web de redes sociales creado por Mark Zuckerberg y fundado junto a Eduardo Saverin, Chris Hughes y Dustin Moskovitz.. Su propósito era diseñar un espacio en el que los alumnos de dicha universidad pudieran intercambiar una comunicación fluida y compartir contenido de forma sencilla a través de Internet. Fue tan innovador su proyecto que con el tiempo se extendió hasta estar disponible para cualquier usuario de la red.
-
Las novedosas interfaces entre máquinas y sistemas vivos de Michel Maharbiz podrían dar lugar a una nueva generación de dispositivos cyborg. como prótesis, memorias, biochips, nanotecnologia.
-
las empresas de electrónica y de producción de 3-D están exhibiendo el potencial del contenido de 3-D con la esperanza de que la televisión 3-D doméstica se transforme en un elemento de consumo en un par de años. La experiencia de ver una película en 3-D cambió mucho en las últimas décadas.
-
El sistema MultiAir permite y determina electrónicamente la manera más eficiente de abrir y cerrar las válvulas, dependiendo de las condiciones de la carretera y de la potencia necesaria, permitiendo que el coche funcione más eficientemente a todas las velocidades.
-
En el Reino Unido, varios investigadores han desarrollado la tarjeta MyCare, que es aproximadamente del tamaño y forma de una tarjeta de crédito, con un conector USB desplegable. Otro proyecto, SmartCare, que empezó a aplicarse en Zambia, se ha extendido recientemente a Etiopía y Sudáfrica, y demuestra el potencial de los sistemas basados en tarjetas en partes del mundo con una infraestructura limitada.
-
Gracias a los ordenadores, el software de reconocimiento de voz ha logrado automatizar el trabajo de convertir las palabras dichas por un médico en texto.
-
vehículos propulsados por uno o más motores eléctricos. La tracción puede ser proporcionada por ruedas o hélices impulsadas por motores rotativos, o en otros casos utilizar otro tipo de motores no rotativos,sus ventajas No producen contaminación atmosférica.No producen contaminación sonora.
Su uso permite prescindir de combustible y así ahorra petróleo, una materia prima limitada y se puede dedicar a otras materias también necesarias.Su mantenimiento es muy fácil. -
La primera red eléctrica inteligente completa a gran escala ya está operando. El proyecto, ha costado 800 millones de dólares y se ha construido en Florida (EEUU), ha servido para que los apagones sean más cortos y menos frecuentes, y según la compañía eléctrica que la opera.Las redes inteligentes deberían ser mucho más resistentes que las redes convencionales, algo importante para sobrevivir a tormentas y facilitar la instalación de más fuentes de energía intermitente, como la energía solar.
-
Trata la intermitencia de las energías renovables será crucial para su expansión. y para que haya menos contaminación ambiental.
-
Varios pacientes de leucemia ya se han curado mediante una técnica que modifica genéticamente las células-T en la que Novartis ya ha mostrado su interés por medio de la biotecnologia aplicada en la medicina
-
la inteligencia humana se unirá en una gran inteligencia colectiva y de que el protagonismo de pues dentro de diez o quince años podremos comunicarnos telepáticamente en cuestión de segundos. que ira reemplazando la mente humana.
Looking for a timeline maker?
Create timelines for projects, roadmaps, history, lessons, legal cases, and stories with Timetoast. Timetoast is a timeline maker for work, school, research, and stories.